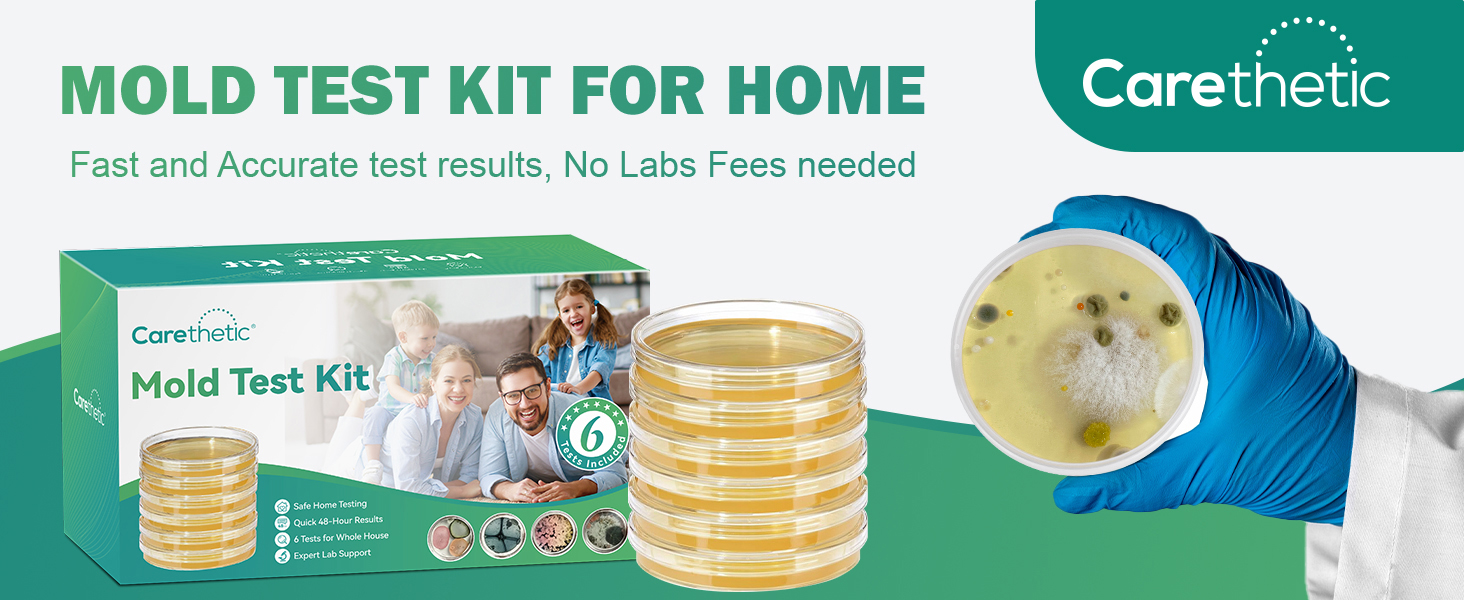

Carethetic Mold Test Kit for Home, 6 DIY Agar Plates for Air, HVAC and Surface Testing, Indoor Mold Testing Kit with Swabs, Gloves, Bags and User Manual
Special Features
Fast & Simple: Collect samples in minutes with clear instructions - perfect for beginners.
Reliable Results: Professional lab analysis ensures accuracy you can trust.
Versatile Testing: Test walls, furniture, air vents, and more for complete coverage.
Peace of Mind: Identify issues early to gain insight into your home's air quality.
{"error":"Error","cart_limit":"You have too many items in your cart.","prod_limit":"You cannot add any more of this item"}
{"email":"Please enter your email address","email_i":"Invalid email address"}
Copyright © Tilga 2026, all rights reserved.